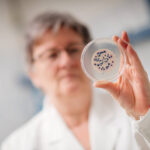

Wasser ist das wichtigste Element unseres Lebens. Hahn auf – sauber und frisch fließt es in gewünschter Menge. Woher kommt das Erfurter Wasser? Welchen Weg nimmt es vom Ursprung bis zu uns nach Hause? Wer prüft Qualität und Inhaltsstoffe? Wie sicher sind wir als Verbraucher? Wir sind den Fragen auf den Grund gegangen und dem Erfurter Wasser auf seinem Weg vom Ursprung bis zum Verbraucher gefolgt.
Thüringer Original aus dem grünen Herzen Deutschlands
Wir beginnen im Thüringer Wald, dem wichtigsten Wasserreservoir des Freistaates. Bereits 1921 gründeten verschiedene Städte mit der Reichsbahn und der Landesanstalt für Gewässerkunde eine Arbeitsgemeinschaft, um Talsperren zu errichten und eine zukunftssichere Versorgung für die Einwohner und die wachsende Industrie aufzubauen. Ziel war es, das jahreszeitlich schwankende Wasseraufkommen und die dadurch wechselnde Qualität auszugleichen, außerdem dienten die Talsperren dem Hochwasserschutz. Thüringen ist ein wasserreiches Land, heute findet man im Freistaat zahlreiche dieser Ingenieurbauwerke: Luisenthal, Tambach-Dietharz, Scheibe-Alsbach oder Leibis …
Unterwegs auf den Spuren des Erfurter Trinkwassers: Nach weniger als einer Stunde Fahrt von Erfurt erreichen wir die Ohra-Talsperre am Rande des beschaulichen Örtchens Luisenthal. Der Staudamm hat sich in die bewaldeten Hänge geschnitten, das kleine Flüsschen Ohra füllt den Speicher. Mehr als 17 Mio. m³ fasst das Wasserreservoir, das zu einem Verbund mit den beiden Tambach-Dietharzer Talsperren gehört. Seit 1967 kommt aus der Ohra-Talsperre Wasser für Erfurt. Weimar, Jena und andere Thüringer Städte wie Sondershausen beziehen das Lebensmittel Nr. 1 ebenfalls von dort. Eine Fernleitung verbindet seit 1967 Luisenthal mit den Übergabepunkten der örtlichen Versorger: In zwei Tagen ist das Wasser in Erfurt, in ca. sechs in Sondershausen.
Doch von Anfang an: Wie kommt das Wasser aus dem Stausee in die Leitung? Ganz einfach: Inmitten des Sees steht ein Entnahmeturm, von dort wird die Wasserschicht mit der besten Qualität angezapft. Einmal pro Woche wird getestet und über die Entnahmehöhe entschieden.
Ein Strom voller Energie
Direkt hinter der Staumauer steht die Energiegewinnungsanlage, Wasser rauscht in lautem Schwall aus einem Rohr in einen offenen Kanal. Wir werden schon von Wasserfachmann Falko Hallebach erwartet. „1,5 GWh Strom aus Wasserkraft können hier pro Jahr erzeugt werden, das reicht für den Eigenbedarf und eine satte Überschusseinspeisung ins Stromnetz“, erzählt der Leiter des Meisterbereiches Luisenthal der Thüringer Fernwasserversorgung. Wir gehen in die Aufbereitungsanlage, hier wird Rohwasser zu Trinkwasser. Das Wasser wird in riesigen Hochbehältern gespeichert und strömt von dort in die Teilstromaufhärtung. Über Calziumcarbonatfilter geleitet, wird die im Wasser enthaltene aggressive Kohlensäure in Hydrogencarbonat umgewandelt, entsäuert, sagt der Fachmann. „Das vorher noch saure Wasser würde die Rohrleitungen angreifen. Das ebenfalls zugefügte Eisen-(III)-Chlorid bindet kleinste Schmutzpartikel, die dann herausgefiltert werden können. Natronlauge dient zum Einstellen eines konstanten pH-Wertes“, erklärt der Fachmann. Weiter geht es: In der Halle herrscht eine besondere Stille, es ist kühl. In 14 Becken, offenen Mehrschichtfiltern, wird aus dem Rohwasser nun Trinkwasser. Ca. 15 Minuten Verweildauer pro Filter sind notwendig. Trübung, Eisen- und Manganverbindungen sowie Schwebstoffe werden hier auf konstante Werte eingestellt.
Am Ende der Aufbereitung macht sich ein echtes Thüringer Qualitätsprodukt auf den Weg zu den Kunden, verschiedenen Wasserversorgungsunternehmen Thüringens. 67.000 m³ Wasser können täglich aufbereitet werden. Abschließend erhält das Produkt eine Chlorung, damit es seinen langen Weg keimfrei übersteht. Wir nehmen einen frischen Schluck und verabschieden uns von Falko Hallebach.
Aus gutem Grunde und nah am Verbraucher
Während das Ohra-Wasser durch riesige Rohre mit einem Durchmesser von 1 Meter gen Erfurt rauscht, machen wir uns auf den Weg nach Erfurt-Möbisburg zum Wasserwerk der Stadtwerketochter ThüWa ThüringenWasser GmbH. Auf dem mehrere Hektar großen, eingezäunten Grundstück wird Grundwasser gewonnen. In der Leitwarte ist Erfurts Wasserversorgung schematisch dargestellt. Lämpchen blinken, schwankende Balken zeigen Füllstände an, das Telefon klingelt. Wir sind im Herz der Erfurter Wasserversorgung, hier wird auch registriert, welche Wassermenge aus Luisenthal am Übergabepunkt ankommt.
Anschließend steigen wir mit Andreas Degelmann, verantwortlich für die Wassergewinnung der ThüWa, in eine Brunnenkammer hinab: Rohre, Pumpen, Zähler und eine UV-Behandlungsanlage. Wasser sieht man hier nirgendwo, das befindet sich weit unter uns in den wasserführenden Bodenschichten. Die Brunnenfassung ist ein tiefes Rohr mit Bohrungen in verschiedenen Höhen. 15 Tiefbrunnen gibt es im Wasserwerk. In einer Tiefe von 30 m wird heute angezapft und Grundwasser in die Wasserwerksanlagen gepumpt. Entscheidend für die Entnahmehöhe ist die Qualität des Rohwassers. Nach minimaler Chlorierung (ein Zehntel des erlaubten Wertes) und einer Behandlung mit ultravioletten Strahlen strömt das Grundwasser in Richtung der Hochbehälter. 26 gibt es davon im ThüWa-Netz. Sie dienen als Speicher, so kann die Wasserversorgung auf die unterschiedliche Nachfrage im Tagesverlauf reagieren und gleichmäßig liefern. Sie stehen oberhalb der Stadt, das Wasser nutzt für seinen Weg das natürliche Gefälle. Das Prinzip kannten bereits die Erbauer der ersten leitungsgebundenen Wasserversorgung für Erfurt im Jahre 1876.
Wir folgen dem Wasser und fahren zum Hochbehälter Marbach. Zwei Behälterkammern decken den Bedarf für ein Drittel bis ein Viertel der Landeshauptstadt, erklärt Andreas Degelmann. Hier kommt es wie in anderen Hochbehältern auch zum Zusammentreffen des weichen Ohra-Wassers mit dem harten Erfurter Grundwasser. Das Mischen ist ein komplexer Prozess, kräftig sprudelnd treffen beide Wässer in flachen Metallbehältern aufeinander. Wasser soll klar sein, so sagt es auch die Trinkwasserverordnung, und frei von untypischem Geruch oder Geschmack. Mit einer Härte von ca. 11 bis 14 °- also mittel – verlässt das H2O den Mischbehälter.
Wir steigen in eine Kammer des Hochbehälters, die für Wartung und Reinigung entleert wurde. Treppen führen ca. 12 m tief hinab. Hohe Säulen tragen das Bogengewölbe, Optik und Akustik erinnern an eine Kirche. 5000 m³ Wasser werden in ein paar Tagen nach erfolgter Reinigung der Speicherkammer wieder eingefüllt. Wir werfen einen Blick in die zweite, gefüllte Behälterkammer. Das 8 ° Celsius kühle Wasser steht bis ca. drei Meter unter dem Eingang und schillert türkis und klar, fast wie das Meer.
An einem leicht steigenden und fallenden Pegel erkennt man Zu- und Ablauf. Ca. 110 Liter Wasser verbraucht jeder Erfurter pro Tag, im ebenfalls von der ThüWa versorgten Umland sind es 70 Liter. Mehr als 12 Mio. m³ werden pro Jahr für das gesamte Versorgungsgebiet gebraucht. Mehr als 243.000 Verbraucher – von Vehra bis Rockhausen und Döllstädt bis Eckstedt – lassen sich das Lebensmittel Nr. 1, geliefert von der Stadtwerketochter, schmecken. Über das weit verzweigte, ca. 1700 km lange Rohrleitungsnetz kommt das Thüringer Qualitätsprodukt zu ihnen.
Was im Wasser drin ist oder nicht
Apropos Qualität: Woher wissen wir, wie gut das Wasser ist? Das erklärt Andreas Raab, Niederlassungsleiter der GWA in Luisenthal: „Fünf oder sechs Labormitarbeiter sind täglich in Thüringen unterwegs, nehmen Wasserproben an verschiedenen Punkten des Netzes wie z. B. Hochbehältern. Die wichtigsten Parameter der Proben werden noch am selben Tag untersucht.“
Wir schauen mit ihm hinter die Labortüren und lassen uns den Weg der Wasserproben erklären: Ein Teil der Probe kommt auf Nährböden aus dem Geliermittel Agar Agar. Im Normalfall sieht man auf den Nährböden nach mehreren Tagen nichts. Bilden sich darauf farbige Punkte oder Flächen, dann sind Bakterien vorhanden. Coliforme Keime, Escherichia Coli, Enterokokken, Legionellen oder Pseudomonas können so nachgewiesen werden. Sie alle dürfen nicht im Trinkwasser enthalten sein. Unter normalen Umständen sind sie in der Wasserversorgung auch nicht nachweisbar, versichert Andreas Raab. Selbst kleinste Beeinträchtigungen davon müssten dem Gesundheitsamt gemeldet werden, das dann weitere Schritte einleitet.
In den Laborräumen gibt es eine Vielzahl von Geräten, mit denen kleinste Spuren bestimmter Stoffe nachgewiesen werden können. Vieles läuft per Computer automatisch, Messreihen werden aufgezeichnet und anschließend ausgewertet und archiviert. Was passiert mit den Trinkwasserproben? pH-Wert, Leitfähigkeit, Trübung oder Schwermetall und Quecksilber werden untersucht. Außerdem kann auf Spurenstoffe wie Arzneimittelrückstände oder Pflanzenbehandlungsmittel getestet werden. Die Vorgaben der Trinkwasserverordnung sind streng – im Sinne der Verbraucher. Dr. Alexander Perko analysiert das Wasser auf Desinfektionsnebenprodukte und erklärt uns, wie das mit der modernen Labortechnik funktioniert.
Wir wollen die Frage klären, warum in einigen Regionen Medikamentenrückstände im Wasser gefunden werden. Dr. Perko verweist auf die moderne Labortechnik, die minimalste Bestandteile von Spurenstoffen erfasst, oft ein Bruchteil des Erlaubten, noch vor Jahren nicht nachzuweisen.
Erfurts Wasser stammt aus dem Thüringer Wald und aus gutem Grund, aus dem Erfurter Steiger. Im Luisenthaler Labor wird akribisch untersucht und geprüft.
Alle, denen wir bei unserer Reise auf den Spuren des Erfurter Wassers begegnet sind, leisten ihren Beitrag für Qualität und Versorgungssicherheit. Nicht zu vergessen, die Monteure, die das Wassernetz instand halten. Unser Fazit: Erfurts Wasser ist ein echtes Qualitätsprodukt und wir lassen es uns mit gutem Gefühl schmecken!